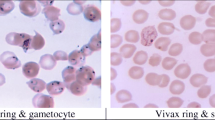

Abstract
Deep learning models have already benchmarked its demonstration in the applications of Medical Sciences. Present day medical industries suffer due to deadly disease such as malaria etc. As per the report from World Health Organization (WHO), it is noted that the amount of caution and care taken per patient by a human doctor to cure malaria is decreasing. To address this issue, this paper proposes an automated solution for the detection of malaria from the real-time image. The key idea of the proposed solution is to use a Deep Convolutional Neural Network (DCNN) called “Falcon” to detect the parasitic cells from blood smeared slide images of Malaria Screener. Furthermore, the class accuracy of the given dataset samples is maintained in order to model not only the normal case but to accurately predict the presence of malaria as well. Experimental results confirms that the model does not possess overfitting, class imbalance, and provides a reasonable classification report and trustworthy accuracy with 95.2 % when compared to the state-of-the-art Convolutional Neural Network (CNN) models.










Similar content being viewed by others
References
Bashir A, Mustafa ZA, Abdelhameid I, Ibrahem R (2017) Detection of malaria parasites using digital image processing. 2017 International Conference on Communication, Control, Computing and Electronics Engineering (ICCCCEE). https://doi.org/10.1109/iccccee.2017.7867644
Chen K, Perlaki C, Xiong A, Preiser P, Liu Q (2016) Review of surface enhanced raman spectroscopy for malaria diagnosis and a new approach for the detection of single parasites in the ring stage. IEEE J Sel Top Quantum Electron 22(4):179–187, Art no. 6900509
Hirimutugoda YM, Wijayarathna G (2009) Artificial intelligence-based approach for determination of haematologic diseases. 2009 2nd International Congress on Image and Signal Processing. https://doi.org/10.1109/cisp.2009.5301750
http://ceb.nlm.nih.gov/repositories/malaria-datasets/, retrieved as on 10.06.2020
Ketout H, Gu J, Horne G (2011) MVN_CNN and UBN_CNN for endocardial edge detection. 2011 Seventh International Conference on Natural Computation. https://doi.org/10.1109/icnc.2011.6022163
Khan A, Khalil A, Hajjdiab H (2018) Mobile microscopic device to detect parasitical cell-related diseases using machine learning. 2018 6th International Conference on Future Internet of Things and Cloud Workshops (FiCloudW). https://doi.org/10.1109/w-ficloud.2018.00029
Kido S, Hirano Y, Hashimoto N (2018) Detection and classification of lung abnormalities by use of convolutional neural network (CNN) and regions with CNN features (R-CNN). 2018 International Workshop on Advanced Image Technology (IWAIT). https://doi.org/10.1109/iwait.2018.8369798
Ogunleye A, Wang Q-G (2018) Enhanced XGBoost-based automatic diagnosis system for chronic kidney disease. 2018 IEEE 14th International Conference on Control and Automation (ICCA). https://doi.org/10.1109/icca.2018.8444167
Penas KED, Rivera PT, Naval PC (2017) Malaria parasite detection and species identification on thin blood smears using a convolutional neural network. 2017 IEEE/ACM International Conference on Connected Health: Applications, Systems and Engineering Technologies (CHASE). https://doi.org/10.1109/chase.2017.51
Peñas KED, Rivera PT, Naval PC (2018) Analysis of convolutional neural networks and shape features for detection and identification of malaria parasites on thin blood smears. Intelligent Information and Database Systems Lecture Notes in Computer Science, pp 472–481. https://doi.org/10.1007/978-3-319-75420-8_45
Sethi K, Parmar V, Suri M (2018) Low-power hardware-based deep-learning diagnostics support case study. 2018 IEEE Biomedical Circuits and Systems Conference (BioCAS). https://doi.org/10.1109/biocas.2018.8584697
Shao L, Zhu F, Li X (2015) Transfer learning for visual categorization: a survey. IEEE Trans Neural Netw Learn Syst 26(5):1019–1034. https://doi.org/10.1109/tnnls.2014.2330900
Shu G, Liu W, Zheng X, Li J (2018) IF-CNN: Image-aware inference framework for CNN with the collaboration of mobile devices and cloud. IEEE Access 6:68621–68633. https://doi.org/10.1109/access.2018.2880196
Stemple CC, Kwon H, Yoon J (2012) Rapid and sensitive detection of malaria antigen in human blood with lab-on-a-chip,. IEEE Sensors J 12(9):2735–2736
Acknowledgements
We would like to thank Dr. S. V. Kota Reddy, Vice Chancellor, VIT-AP University for motivating and helping us to build this project. This research is supported and carried out in Artificial Intelligence and Robotics (AIR) center, Vellore Institute of Technology – Andhra Pradesh, Amaravati, India.
Author information
Authors and Affiliations
Corresponding author
Ethics declarations
Conflict of interest
The authors declare that they have no conflict of interest.
Ethical approval
This article does not contain any studies with human participants or animals performed by any of the authors.
Additional information
Publisher’s note
Springer Nature remains neutral with regard to jurisdictional claims in published maps and institutional affiliations.
Rights and permissions
About this article
Cite this article
Banerjee, T., Jain, A., Sethuraman, S.C. et al. Deep Convolutional Neural Network (Falcon) and transfer learning‐based approach to detect malarial parasite. Multimed Tools Appl 81, 13237–13251 (2022). https://doi.org/10.1007/s11042-021-10946-5
Received:
Revised:
Accepted:
Published:
Issue Date:
DOI: https://doi.org/10.1007/s11042-021-10946-5